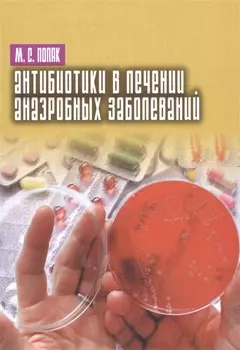
Антибиотики в лечении анаэробных заболеваний

-
 None742 ₽610 ₽-17%
None742 ₽610 ₽-17%Нерешенные и спорные проблемы современной гастроэнтерологии. | В монографии обсуждается ряд актуальных, но не до конца решенных и/или спорных проблем современной клинической гастроэнтерологии, в том ч...
-
 None989 ₽670 ₽-32%
None989 ₽670 ₽-32%Введение в цифровую обработку биомедицинских изображений. Учебное пособие | Учебное пособие содержит информацию об основных методах получения биомедицинских изображений, общие сведения о цифровой обра...
-
 None359 ₽299 ₽-16%
None359 ₽299 ₽-16%Квалифицированная помощь при травме ЧЛО | Пособие посвящено актуальному вопросу помощи при повреждениях челюстно-лицевой области. Оно должно помочь студентам в самостоятельном изучении многообразия кл...
-
 None335 ₽279 ₽-16%
None335 ₽279 ₽-16%Избыточный вес и ожирение: Профилактика диагностика лечение | Монография посвящена диагностике и лечению ожирения, одного из наиболее распространенных и плохо поддающихся терапии заболеваний. С позици...
-
 None565 ₽465 ₽-17%
None565 ₽465 ₽-17%Бактериальный вагиноз | В монографии представлены и обобщены современные данные о патогенезе дисбиотических процессов влагалища, особенностях заболеваний, обусловленных дисбалансом микрофлоры слизисты...
-
 None1415 ₽1163 ₽-17%
None1415 ₽1163 ₽-17%Ревмоортопедия: комплексное восстановительное лечение больных ревматическими заболеваниями | Вашему вниманию предлагается издание "Ревмоортопедия: комплексное восстановительное лечение больных ревмати...
-
 None376 ₽309 ₽-17%
None376 ₽309 ₽-17%Руководство по лазеротерапии стоматологических заболеваний | Второе издание руководства посвящено современному популярному и широко применяемому физиотерапевтическому фактору - лазерному излучению. По...
-
 None978 ₽804 ₽-17%
None978 ₽804 ₽-17%Боль в спине. 2-е издание, переработанное и дополненное | В руководстве приведены современные представления о причинах и механизмах развития боли в спине. Изложены основные методы фармакотерапии и физ...
-
![Безопасность жизнедеятельности и медицина катастроф. Учебное пособие]() None1238 ₽1018 ₽-17%
None1238 ₽1018 ₽-17%Безопасность жизнедеятельности и медицина катастроф. Учебное пособие | Учебное пособие написано в соответствии с Государственным образовательным стандартом для средних медицинских учебных заведений. В...
-
![Полифасцикулярный остеосинтез: атлас]() None978 ₽804 ₽-17%
None978 ₽804 ₽-17%Полифасцикулярный остеосинтез: атлас | В атласе представлена система полифасцикулярного остео-синтеза, подробно изложена методика установки блоков при переломах костей верхней и нижней конечностей. Пр...
-
![Внематочная беременность]() None742 ₽610 ₽-17%
None742 ₽610 ₽-17%Внематочная беременность | В монографии изложены современные представления об этиологии и патогенезе внематочной беременности. Представлена нормальная анатомия и физиология маточных труб, современная ...
-
![Покажи мне как: Мать и дитя]() None599 ₽499 ₽-16%
None599 ₽499 ₽-16%Покажи мне как: Мать и дитя | В этой книге вас ждет масса полезных советов, которые пригодятся любой современной маме. Как одеваться во время беременности, как прийти в себя после родов, как успокоить...
-
![Аритмии сердца. Практические заметки по интерпретации и лече]() None4129 ₽3394 ₽-17%
None4129 ₽3394 ₽-17%Аритмии сердца. Практические заметки по интерпретации и лече | Книга "Аритмии сердца" неоднократно переиздавалась на многих языках и стала настоящим бестселлером во всем мире. Данное издание представл...
-
![Психодиагностика нарушений пространственного внимания / под ред. Л.И.Вассерман, Т.В. Чередниковой]() None648 ₽533 ₽-17%
None648 ₽533 ₽-17%Психодиагностика нарушений пространственного внимания / под ред. Л.И.Вассерман, Т.В. Чередниковой | В монографии кратко освещены значимые для нейропсихологии и медицинской практики вопросы теории одно...
-
![Лучевая диагностика заболеваний желудочно-кишечного тракта]() None6135 ₽4783 ₽-22%
None6135 ₽4783 ₽-22%Лучевая диагностика заболеваний желудочно-кишечного тракта | Всеобъемлющее руководство по лучевой диагностике заболеваний пищевода, желудка, кишечника и брыжейки, включая врожденные аномалии, функцион...
-
![Психофизиологические основы анализа спортивной деятельности методом газоразрядной визуализации (ГРВ)]() None1037 ₽853 ₽-17%
None1037 ₽853 ₽-17%Психофизиологические основы анализа спортивной деятельности методом газоразрядной визуализации (ГРВ) | В монографии рассматриваются психофизиологические основы анализа спортивной деятельности с примен...
-
![Биодеградируемые изделия на основе фиброина шелка для тканевой инженерии и регенеративной медицины]() None1096 ₽901 ₽-17%
None1096 ₽901 ₽-17%Биодеградируемые изделия на основе фиброина шелка для тканевой инженерии и регенеративной медицины | В монографии представлены современные результаты исследования структуры и биологических свойств изд...
-
![Фармакокоррекция иммунотоксического действия пестицидов. Монография]() None1096 ₽901 ₽-17%
None1096 ₽901 ₽-17%Фармакокоррекция иммунотоксического действия пестицидов. Монография | Монография объединяет результаты научных исследований авторов, связанных с изучением иммунотоксичности пестицидов и поиском средст...
-
![Медицинская статистика: учебное пособие]() None648 ₽505 ₽-22%
None648 ₽505 ₽-22%Медицинская статистика: учебное пособие | В учебном пособии представлены основы математической статистики для анализа медицинских данных, отражены основные педагогические проблемы, возникающие при ее ...
-
![Фармакология может быть доступной. Иллюстрированное пособие для врачей и тех, кто хочет ими стать]() None2359 ₽1939 ₽-17%
None2359 ₽1939 ₽-17%Фармакология может быть доступной. Иллюстрированное пособие для врачей и тех, кто хочет ими стать | В книге представлена информация по всем разделам общей и частной фармакологии. Описаны препараты, вк...
-
![Карцинома Меркеля. Клинические рекомендации]() None648 ₽505 ₽-22%
None648 ₽505 ₽-22%Карцинома Меркеля. Клинические рекомендации | Издание представляет собой официальные клинические рекомендации последнего пересмотра (2019) и включает основную информацию по карциноме Меркеля. В отдель...
-
![Гематология Национальное руководство]() None6843 ₽5335 ₽-22%
None6843 ₽5335 ₽-22%Гематология Национальное руководство | Национальное руководство по гематологии содержит всестороннюю информацию о диагностике и лечении болезней системы крови, направленную на облегчение трансляции не...
-
![Тубулоинтерстициальные изменения при хронических заболеваниях почек у детей]() None683 ₽533 ₽-21%
None683 ₽533 ₽-21%Тубулоинтерстициальные изменения при хронических заболеваниях почек у детей | В книге обобщены исследования авторов и литературные данные, касающиеся роли тубулоинтерстициальных изменений и других фак...
-
![Патофизиология крови]() None1533 ₽1260 ₽-17%
None1533 ₽1260 ₽-17%Патофизиология крови | Монография является кратким руководством по физиологии и патофизиологии крови и системы кровотворения. В ней представлены современные данные о развитии клеток крови, их функцион...
-
![Ортодонтия. Национальное руководство. В двух томах. Том 2. Лечение зубочелюстных аномалий]() None7433 ₽5795 ₽-22%
None7433 ₽5795 ₽-22%Ортодонтия. Национальное руководство. В двух томах. Том 2. Лечение зубочелюстных аномалий | ИздРуководство посвящено лечению зубочелюстных аномалий. В нем описаны основные методы лечения: ортодонтичес...
-
![Фантомы мозга]() None1096 ₽901 ₽-17%
None1096 ₽901 ₽-17%Фантомы мозга | В.С. Рамачандран – всемирно известный невролог, психолог, доктор медицины, доктор философии, директор Исследовательского центра высшей нервной деятельности, профессор психологии и нейр...
-
![Диагностические индексы в дерматологии]() None2123 ₽1745 ₽-17%
None2123 ₽1745 ₽-17%Диагностические индексы в дерматологии | Книга посвящена систематизации количественной оценки дерматологических заболеваний. Во второе издание вошли зарекомендовавшие себя на практике и ставшие класси...
-
![На грани срыва: исповедь анестезиолога-реаниматолога]() None565 ₽465 ₽-17%
None565 ₽465 ₽-17%На грани срыва: исповедь анестезиолога-реаниматолога | Юрий Борисович Жидков родился в 1957 году в г. Макарьев Костромской области. Окончил Ленинградский педиатрический медицинский институт. Юрий Жидк...
-
![Рак яичников: фундаментальные и клинические исследования. Монография]() None5191 ₽4267 ₽-17%
None5191 ₽4267 ₽-17%Рак яичников: фундаментальные и клинические исследования. Монография | Монография посвящена анализу современных представлений о патогенетических механизмах развития рака яичников - одной из важнейших ...
-
![Атриовентрикулярные блокады. Клиника, диагностика, показания к электрокардиотерапии]() None263 ₽219 ₽-16%
None263 ₽219 ₽-16%Атриовентрикулярные блокады. Клиника, диагностика, показания к электрокардиотерапии | Эта книга продолжает серию публикаций "От ЭКГ к диагнозу". .Книга предназначена для студентов медицинских вузов, и...
-
![Паллиативная медицина. Сестринский уход. Пособия для мед. сестер]() None459 ₽377 ₽-17%
None459 ₽377 ₽-17%Паллиативная медицина. Сестринский уход. Пособия для мед. сестер | В пособии рассматриваются принципы диагностики, профилактики и лечения, особенности общего и специализированного сестринского ухода п...
-
![Заболевания межпозвонковых дисков]() None5899 ₽4849 ₽-17%
None5899 ₽4849 ₽-17%Заболевания межпозвонковых дисков | Настоящее руководство посвящено заболеваниям, в основе которых лежат патологические процессы, происходящие в межпозвонковых дисках. В книге детально рассматриваются...
-
![Вообще чума! И эпидемии нашего времени]() None860 ₽707 ₽-17%
None860 ₽707 ₽-17%Вообще чума! И эпидемии нашего времени | Откуда можно узнать о чуме и хорее Гентингтона, склерозе и болезни Паркинсона, синдроме Стендаля и загадочной бери-бери? Из медицинского справочника заболевани...
-
![Меланоцитарные и меланиновые поражения кожи: учебное пособие]() None1651 ₽1357 ₽-17%
None1651 ₽1357 ₽-17%Меланоцитарные и меланиновые поражения кожи: учебное пособие | Пигментные поражения кожи имеет каждый человек. По этой причине эта область медицины всегда привлекает к себе внимание. В книге рассмотре...
-
![Пожилой человек: Сестринский уход: Пособие для медицинских сестер]() None412 ₽339 ₽-17%
None412 ₽339 ₽-17%Пожилой человек: Сестринский уход: Пособие для медицинских сестер | Пособие подготовлено коллективом авторов Санкт-Петербургской медицинской академии последипломного образования и Городского гериатрич...
-
![Локальное лечение боли]() None1533 ₽1260 ₽-17%
None1533 ₽1260 ₽-17%Локальное лечение боли | Книга представляет собой своеобразный атлас, в котором освещается лечение боли с помощью местноанестезирующих средств - один из самых эффективных и быстрых видов устранения бо...
-
![Партитура смерти. Случаи из практики самого известного судмедэксперта Германии]() None919 ₽756 ₽-17%
None919 ₽756 ₽-17%Партитура смерти. Случаи из практики самого известного судмедэксперта Германии | Самый известный патологоанатом Михаэль Тсокос снова берется за раскрытие громких дел. В этой книге - не только резонанс...
-
![Школа молодого психиатра: Избранные главы общей психопатологии и частной психиатрии.]() None2241 ₽1842 ₽-17%
None2241 ₽1842 ₽-17%Школа молодого психиатра: Избранные главы общей психопатологии и частной психиатрии. | В книге изложен опыт преподавания общей психопатологии и частной психиатрии молодым врачам при прохождении ими ин...
-
![Клиническая электрокардиография /2-е изд.]() None2713 ₽2230 ₽-17%
None2713 ₽2230 ₽-17%Клиническая электрокардиография /2-е изд. | Второе издание книги соответствует второму изданию бестселлера Ф.Циммермана "Клиническая электрокардиография" на языке оригинала, выпушенному в 2006 году. В...
-
![Фармакология. Учебник]() None5333 ₽2550 ₽-52%
None5333 ₽2550 ₽-52%Фармакология. Учебник | Учебник состоит из двух частей. Учебник состоит из двух частей. В первой части, "Общей фармакологии", представлены основные закономерности, определяющие влияние как л...
-
![Антибиотики в лечении анаэробных заболеваний]() None471 ₽387 ₽-17%
None471 ₽387 ₽-17%Антибиотики в лечении анаэробных заболеваний | Антибиотикотерапия является важным компонентом комплекса лечебных мероприятий при заболеваниях, вызванных облигатно анаэробными бактериями (родов Bactero...
-
![Избранные лекции по профессиональной патологии у военнослужащих. Учебное пособие]() None2949 ₽2424 ₽-17%
None2949 ₽2424 ₽-17%Избранные лекции по профессиональной патологии у военнослужащих. Учебное пособие | Учебное пособие написано авторским коллективом кафедры военно-полевой терапии Военно-медицинской академии им. С. М. К...
-
![Видеоэндоскопические методы нефрэктомии при заболеваниях почек и верхних мочевых путей]() None1002 ₽781 ₽-22%
None1002 ₽781 ₽-22%Видеоэндоскопические методы нефрэктомии при заболеваниях почек и верхних мочевых путей | Книга посвящена видеоэндоскопическим методам органоуносящих операций при различных доброкачественных и злокачес...
-
![Кардиотокография при беременности и в родах. 5-е издание]() None1474 ₽1212 ₽-17%
None1474 ₽1212 ₽-17%Кардиотокография при беременности и в родах. 5-е издание | В учебном пособии представлены основополагающие данные об основных показателях кардиотокографии, изложены их патофизиологические и клинически...
-
![Наглядная магнитно-резонансная томография]() None2595 ₽2023 ₽-22%
None2595 ₽2023 ₽-22%Наглядная магнитно-резонансная томография | Вы держите в руках переводное издание книги «Наглядная магнитно-резонансная томография», получившей книжную премию Британской медицинской ассоциации в 2016 ...
-
![Дифференциальная диагностика при ультразвуковых исследования]() None7315 ₽6013 ₽-17%
None7315 ₽6013 ₽-17%Дифференциальная диагностика при ультразвуковых исследования | Книга является весьма исчерпывающим руководством по дифференциальной диагностике при УЗИ, отличающимся от прочих подобных изданий четкой ...
-
![Из дневников практического врача. Путь к познанию информационной медицины и клинической паразитологии]() None1474 ₽1212 ₽-17%
None1474 ₽1212 ₽-17%Из дневников практического врача. Путь к познанию информационной медицины и клинической паразитологии | В книге автор представил своё понимание ЭнергоИнформационного обмена человека, о роли Эпифиза, Ш...
-
![Атлас рентгенологических укладок. Мёллер 2008 г. 320 с.]() None2123 ₽1655 ₽-22%
None2123 ₽1655 ₽-22%Атлас рентгенологических укладок. Мёллер 2008 г. 320 с. | Атлас рентгенологических укладок известных немецких авторов в простой и наглядной форме представляет способы получения качественного рентгенов...
-
![Респираторная поддержка пациентов в критическом состоянии: руководство для врачей]() None4837 ₽3771 ₽-22%
None4837 ₽3771 ₽-22%Респираторная поддержка пациентов в критическом состоянии: руководство для врачей | В руководстве предложены инновационные, наиболее эффективные алгоритмы ранней диагностики и прецизионного лечения тя...
-
![Организация и оснащение стоматол. поликлиники, кабинета]() None978 ₽804 ₽-17%
None978 ₽804 ₽-17%Организация и оснащение стоматол. поликлиники, кабинета | Учебное пособие содержит систематическое изложение материала по организации и оборудованию стоматологической поликлиники, кабинета: эргономиче...
-
![Ультразвуковая диагностика в цифрах Издание 3]() None589 ₽459 ₽-22%
None589 ₽459 ₽-22%Ультразвуковая диагностика в цифрах Издание 3 | В справочно-практическом руководстве приведены и систематизированы планиметрические (размерные) и количественные показатели внутренних органов при ультр...
-
![Техника лабораторных работ в медицинской практике]() None1356 ₽1115 ₽-17%
None1356 ₽1115 ₽-17%Техника лабораторных работ в медицинской практике | В книге приводятся сведения о современных требованиях к организации выполнения работ в клинико-диагностической лаборатории, о лабораторной посуде и ...
-
![Скорая медицинская помощь. Настольная книга врача]() None683 ₽562 ₽-17%
None683 ₽562 ₽-17%Скорая медицинская помощь. Настольная книга врача | В удобном для чтения руководстве по спасению людей практически в полном объеме собраны сведения о случаях детских и взрослых заболеваний, наиболее ч...
-
![Факторы риска и заболевания сердечно-сосудистой системы у сп]() None742 ₽610 ₽-17%
None742 ₽610 ₽-17%Факторы риска и заболевания сердечно-сосудистой системы у сп | В монографии рассматриваются вопросы адаптационных изменений и дезадаптационных нарушений сердечно-сосудистой системы при занятиях спорто...
-
![Изменения системы крови в клинической практике]() None801 ₽659 ₽-17%
None801 ₽659 ₽-17%Изменения системы крови в клинической практике | В монографии рассматриваются наиболее частые причины изменений системы крови в общеклинической практике. Обсуждаются частота, этиология и патогенез, кл...
-
![Синдром длительного сдавления]() None1356 ₽1057 ₽-22%
None1356 ₽1057 ₽-22%Синдром длительного сдавления | Серия SMART – новое поколение изданий для практикующих врачей. Каждая нозология или метод включает описание патогенеза, нозологического профиля, протоколы лечения и ссы...
-
![Манипуляции в сестринском деле: учеб.пособие дп]() None506 ₽416 ₽-17%
None506 ₽416 ₽-17%Манипуляции в сестринском деле: учеб.пособие дп | Учебное пособие "Манипуляции в сестринском деле" включает алгоритмы выполнения сестринских манипуляций, которые осваивают студенты средних медицинских...
-
![Психические расстройства и расстройства поведения (F00-F99) (Класс V МКБ-10, адаптированный для использования в Российской Федерации)]() None2477 ₽2036 ₽-17%
None2477 ₽2036 ₽-17%Психические расстройства и расстройства поведения (F00-F99) (Класс V МКБ-10, адаптированный для использования в Российской Федерации) | Адаптированный вариант Класса V МКБ-10 подготовлен авторским кол...
-
![Технология изготовления лекарственных форм. Жидкие гетерогенные лекарственные формы. Учебное пособие]() 549 ₽362 ₽-34%
549 ₽362 ₽-34%Технология изготовления лекарственных форм. Жидкие гетерогенные лекарственные формы. Учебное пособие | Данное пособие содержит краткое изложение теоретических основ изготовления и свойств жидких гетер...
-
![Как родить здорового малыша]() None530 ₽436 ₽-17%
None530 ₽436 ₽-17%Как родить здорового малыша | Эти вопросы задает себе любая женщина, собирающаяся стать матерью: Как родить здорового малыша? Как избежать утренней тошноты и плохого самочувствия во время беременности...
-
![Атеросклероз и его осложнения со стороны сердца,мозга и аорты Издание 2]() None239 ₽199 ₽-16%
None239 ₽199 ₽-16%Атеросклероз и его осложнения со стороны сердца,мозга и аорты Издание 2 | Книга содержит современные взгляды на проблему атеросклероза, подтвержденные не только данными литературы, но и собственным кл...
-
![Нанолекарства. Концепции доставки лекарств в нанонауке]() None1002 ₽824 ₽-17%
None1002 ₽824 ₽-17%Нанолекарства. Концепции доставки лекарств в нанонауке | Эта своевременная книга представляет собой обзор возможных терапевтических приложений. В первой части книги освещаются общие свойства и явления...
-
![Артросиндесмология: учебное пособие для медицинских вузов (на английском языке)]() None365 ₽284 ₽-22%
None365 ₽284 ₽-22%Артросиндесмология: учебное пособие для медицинских вузов (на английском языке) | Данное пособие является английской версией учебника профессора И.В. Гайворонского «Нормальная анатомия человека», кото...
-
![Физиотерапия и курортология. Книга II]() None1061 ₽872 ₽-17%
None1061 ₽872 ₽-17%Физиотерапия и курортология. Книга II | В книге 2 описано применение природных и преформированных физических факторов для профилактики, лечения и медицинской реабилитации больных с заболеваниями терап...
Учебники по фармакологии - распродажа
В категории "учебники по фармакологии" найдено товаров: 1233